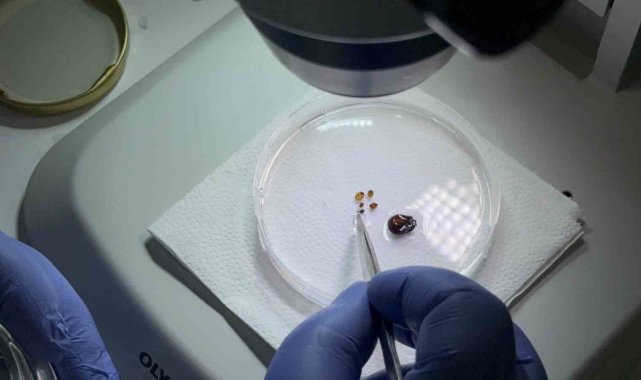

Tokat Gaziosmanpaşa Üniversitesi (TOGÜ) Fen-Edebiyat Fakültesi Biyoloji Bölüm Başkanı Prof. Dr. Adem Keskin, iklim düzensizliği ve küresel ısınmanın etkisiyle kene sezonunun uzadığını ve bu nedenle Kırım Kongo Kanamalı Ateşi (KKKA) riskinin artabileceğini söyledi.Prof. Dr. Keskin, havaların ısınmasıyla birlikte kenelerin daha erken aktif hale geldiğini ve KKKA vakalarının görülmeye başladığını belirterek, özellikle bahar ve yaz aylarında kırsal alanlara giden vatandaşların dikkatli olması gerektiğini ifade etti. Açık renkli kıyafetlerin tercih edilmesi, pantolon paçalarının çorap içine alınması ve vücudu örten uzun kollu giysilerin kullanılmasının önemli olduğunu vurgulayan Keskin, kene kovucu ürünlerin de koruyucu etkisine dikkat çekti.İklim düzensizliği ve küresel ısınma kenelerin dağılımlarını genişletiyorİklim düzensizliği ve küresel ısınmanın yalnızca kene popülasyonunu artırmadığını, aynı zamanda coğrafi yayılımını da genişlettiğini belirten Prof. Dr. Keskin, "Hyalomma marginatum türü, KKKA hastalığının ana taşıyıcısıdır. Türkiye'de özellikle Kelkit Vadisi ve İç Anadolu'nun kuzey kesimleri bu tür için doğal yaşam alanı ve daha yoğun görüldüğü bölgelerdir. Son yıllarda bu türün göçmen kuşlar aracılığıyla Avrupa'ya taşındığını, yayılım alanını genişlettiğini ve iklim düzensizliği ve küresel ısınmaya bağlı olarak gittiği ülkelerde kalıcı olduğunu görüyoruz. Avrupa'nın birçok ülkesinde KKKA hastalığı taşıyan Hyalomma marginatum türü kayıtlanmaya başlandı. Önümüzdeki yıllarda KKKA vakaları Avrupa'da daha sık görülecek" dedi.İklimle birlikte kene takvimi de değiştiToprak sıcaklığının 10-15 derecenin üzerine çıkmasıyla kenelerin aktif hale geldiğini, 20 derece civarında ise yoğun şekilde konak aradıklarını belirten Keskin, "Kış aylarının kısalması ve sonbaharın uzamasıyla birlikte kene sezonu nisan ayından başlayıp eylül-ekim aylarına kadar devam ediyor" diye konuştu.Keskin ayrıca uygun iklim şartlarının kenelerin yıl içinde daha fazla nesil üretmesine yol açabileceğini belirterek, bunun da kene popülasyonunda artışa neden olabileceğini söyledi.
Gündem
Yayınlanma: 30 Nisan 2026 - 09:18
Güncelleme: 30 Nisan 2026 - 09:51
Tokat'ta uzmanından kene uyarısı: İklim düzensizliği ve küresel ısınma kene sezonunu uzatıyor
Tokat Gaziosmanpaşa Üniversitesi (TOGÜ) Fen-Edebiyat Fakültesi Biyoloji Bölüm Başkanı Prof. Dr. Adem Keskin, iklim düzensizliği ve küresel ısınmanın etkisiyle kene sezonunun uzadığını ve bu nedenle Kırım Kongo Kanamalı Ateşi (KKKA) riskinin artabileceğini söyledi.
Gündem
30 Nisan 2026 - 09:18
Güncelleme: 30 Nisan 2026 - 09:51